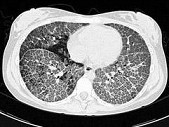

试题详情
- 单项选择题女,18岁, 呼吸困难,消瘦, 糖原PAS染色阳性,结合图像, 最可能的诊断是 ( )
A、系统性红斑狼疮
B、肺泡癌
C、含铁血黄素沉着症
D、肺泡性肺水肿
E、肺泡蛋白沉积症
关注下方微信公众号,搜题查看答案

热门试题
- 支气管扩张的好发部位为 ( )
- 肺转移瘤最常见的表现形式是 (
- 游离性胸腔积液X线表现描述错误的是A、患
- 女,1天早产儿, 呼吸困难、发绀,结合图
- 对肺内球形病灶所致的血管集束征,下列描述
- 男性,58岁,单位年度体检胸片示右上肺第
- 有关腺样囊性癌描述,错误的是 (
- 支气管肺炎的CT表现包括A、可形成空洞B
- 可出现爆米花样钙化的是( )。A、肺
- 肺脓肿的可能病因包括A、上呼吸道感染的脓
- 结缔组织疾病的共同特点为 (
- 关于早期周围型肺癌的描述,下列哪项是正确
- 在诊断中心型肺癌方面,MRI表现有
- 肺结核病灶是否属开放性的主要依据是A、胸
- 典型结核结节中心组织结构是:①肉芽组织,
- 男,47岁。胸痛,渐进性呼吸困难3月。M
- 肺癌中易于发生肺内及胸膜转移的组织学类型
- 系统性红斑狼疮的胸片有以下特点A、肺部游
- 标准立位胸片,气胸线位于肺野外1/3处,
- 肺动静脉瘘的特点为A、透视下可见搏动B、